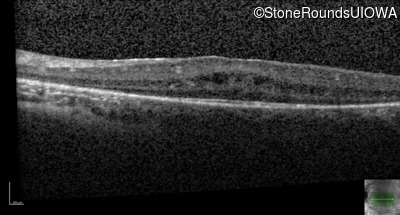
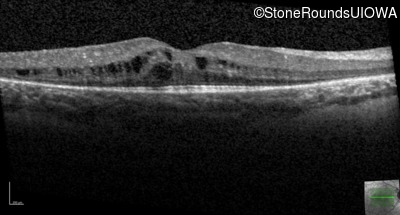
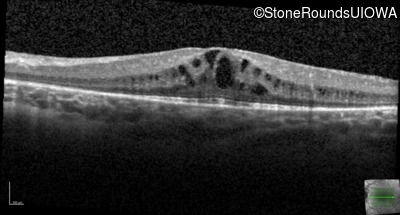
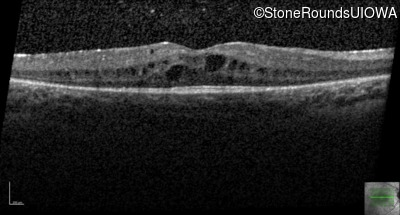
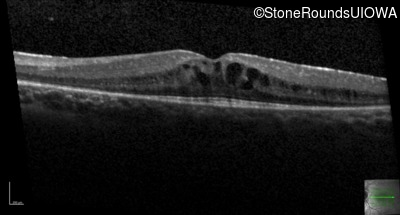
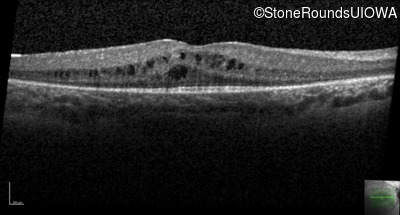
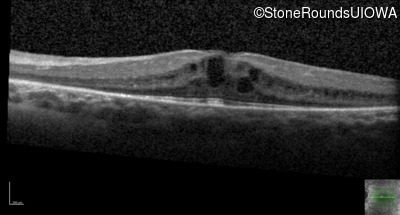
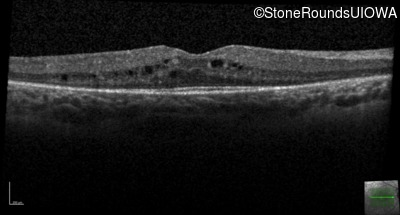
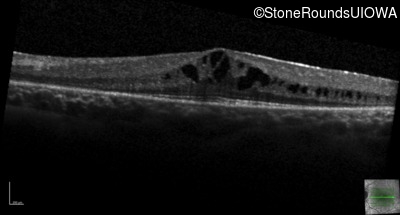
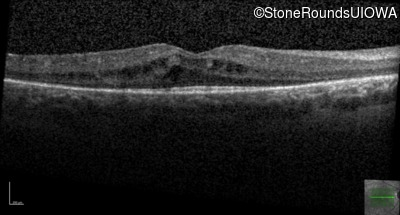
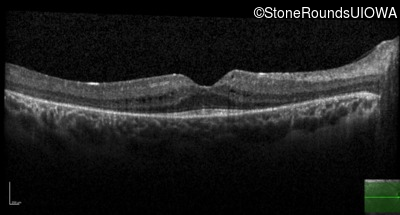
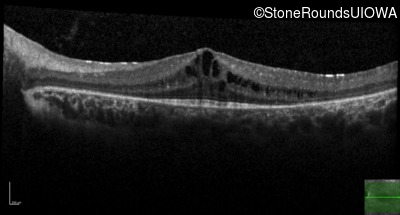
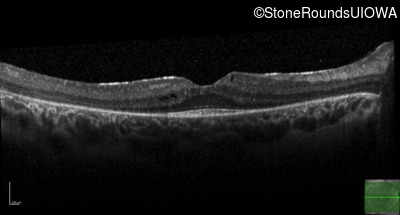
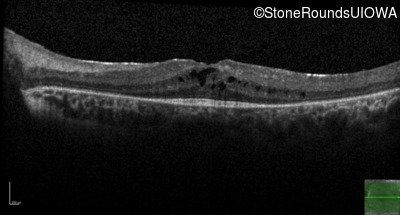
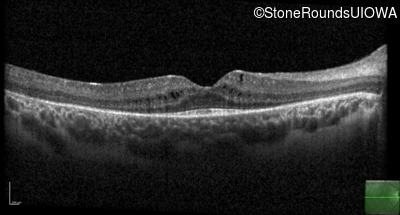
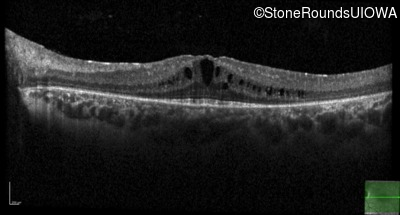
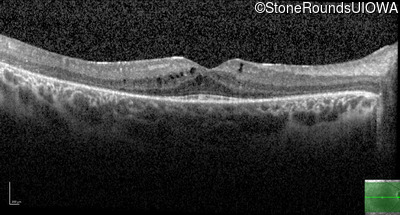
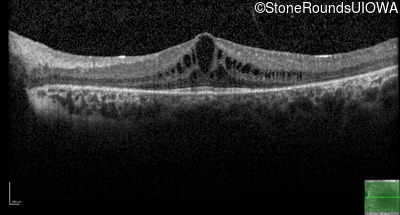
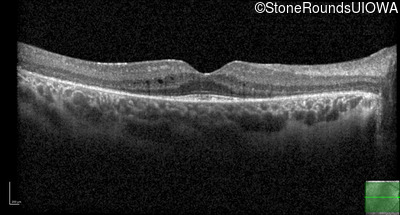
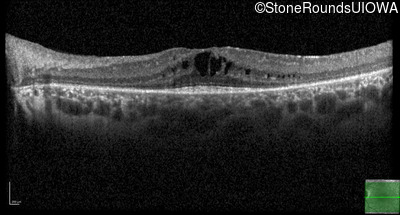
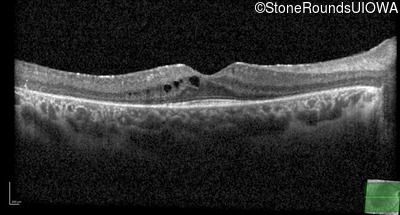
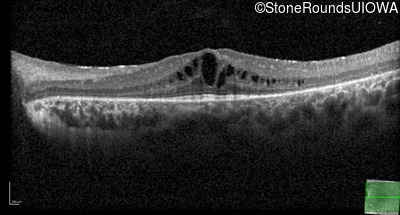
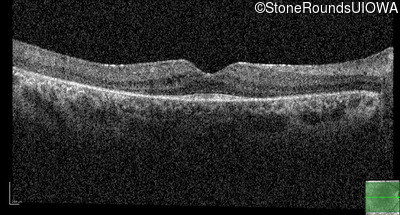
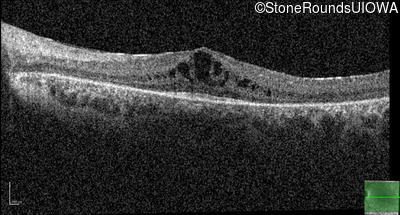

Case
SR806
Student Mode
Leber Congenital Amaurosis (IA2a)
Female
Female
Hidden
SR806
Student Mode
Leber Congenital Amaurosis (IA2a)
Female
Female
History
This 7 year old girl has had very poor vision in dim light and slightly subnormal acuity her entire life.
| Age at visit: 7 years |
| Age at visit: 7 years (Visit 2) |
| Age at visit: 8 years |
| Age at visit: 9 years |
| Age at visit: 12 years |
| Age at visit: 15 years |
| Age at visit: 16 years |
| Age at visit: 17 years |
Diagnosis & molecular findings
| Disease | Gene | Allele 1 variant(s) | Allele 2 variant(s) | Inheritance mode |
|---|---|---|---|---|
| Leber Congenital Amaurosis | RNU6-9 | n.55_56ins1cG | AD |